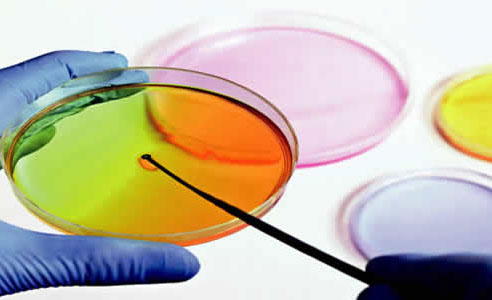

NORMATIVIDAD

<
>
SEROLMA S.A. de C.V. es una empresa especializada en proveer productos de limpieza, sanitización y de mantenimiento industrial, comprometida con la satisfacción de sus clientes y con la protección al medio ambiente.
Por lo tanto, y en cumplimiento a la normatividad aplicable, nuestros productos superan los estándares establecidos en la NOM-028-STPS-2012 que regula el manejo de sustancias químicas y la NOM-018-STPS-2000 que establece las reglas para la identificación y comunicación de riesgos por el manejo de sustancias químicas.
Adicionalmente, Serolma S.A. de C.V. establece los siguientes compromisos:
- • Cumplir con las normas y leyes de seguridad y salud, así como los requisitos y estándares y compromisos definidos voluntariamente sobre la materia.
- • Evaluar y mejorar continuamente nuestros procesos, a fin de prevenir y reducir la contaminación, eliminar los riesgos de inseguridad y garantizar la salud de quienes usen directa o indirectamente nuestros productos.
- • Garantizar que nuestros productos sean amigables con el planeta mediante el uso de sustancias bio-degradables que no afecten los ambientes naturales, el suelo y el aire que respiramos.
SEROLMA S.A DE C.V.
Retorno del Leñador No 30 • Bosques de la Hacienda Primera Sección
Cuautitlán Izcalli • Estado de México • C.P. 54715
Tels. 58937005 / 26022989 / 26028005
ventas@serolma.com / www.serolma.com



